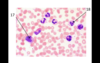

Bio 211 Mid-Term Practical (Prof-Spec) Flashcards
(25 cards)
1
Q

A
- External acoustic meatus
Transports soundwaves to the tympanic membrane
- Auditory tube
A passageway that connects the nasopharynx with the middle ear cavity; also called eustachian tube or pharyngeal tympanic tube.
2
Q

A
- Anterior Semicircular Canal
semicircular duct is one of the three interconnected tubes located inside the ear.
- Cochlea
3
Q

A
- Vestibulocochlear Nerve
6.Stapes
4
Q

A
- Cochlear duct; filled with endolymph
- tectorial membrane
5
Q

A
9.Optic Nerve ; cranial nerve II. transmits visual information from the retina to the brain.
(Optic nerve sheath)
10.Cilliary muscle; the structure that releases a transparent liquid called the aqueous humor, within the eye.
6
Q

A
- Fibrous Layer
- Vascular layer
7
Q

A
- Lacrimal Sac; conveys fluid into the nasal cavity.
- Lateral rectus muscle
8
Q

A
- scala of the vestibule
- external hair cell
(with auditory hairs)
9
Q
A
- Lymphocyte
- Monocyte
10
Q

A
- Great cardiac vein
- Ligamentum arteriosum
11
Q

A
- Left coronary artery
- left pulmonary veins
(opposite blue is artery, vein is red)
12
Q

A
- Brachiocephalic truck
- Aortic valve
13
Q

A
23.
24.Left common carotid artery
14
Q

A
- mitral vavle
- epicardium (layer)
15
Q

A
- R. Axillary atery
- R. Ulnar atery
16
Q

A
- Common carotid arteries
- Left subclavian atery
17
Q

A
- L. gastric artery
- Splenic Artery
18
Q

A
- R. internal iliac artery
- R. anterior tibial artery
19
Q

A
- great saphenous vein (superficial)
- internal iliac vein
20
Q

A
- Right gonadal vein
- common iliac vein
21
Q

A
- R. Renal veins
- L. External iliac vein
22
Q

A
- superior mesenteric vein
- hepatic vein
23
Q

A
- R. Brachial vein
- R radial vein
24
Q

A
- Brachiocephalic vein
- Right subclavican vein
25

49. thoracic duct
50. cisterna chyli


